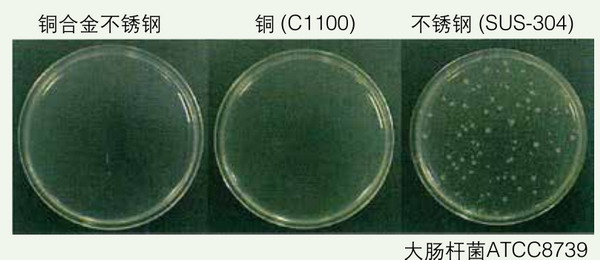
日本松下(原三洋)二氧化碳培養(yǎng)箱MCO-18AC，容積：170L

日本松下(原三洋)二氧化碳培養(yǎng)箱MCO-18AC,容積:170L
日本松下(原三洋)二氧化碳培養(yǎng)箱MCO-18AC,容積:170L | 時間: July-9 15:22:36 | 分類:其它儀器
凌儀生物提供高速離心機(jī),美國Bio-rad伯樂電泳,德國eppendorf艾本德移液器,美國ABI基因擴(kuò)增儀PCR,雅培原位雜交儀,Thermo熱電離心機(jī)等實(shí)驗室儀器設(shè)備,以及Corning康寧,Axygen愛思進(jìn),Greiner格瑞拉等耗材要省錢,別錯過哦。 
產(chǎn)品特點(diǎn):?
抗菌銅合金內(nèi)膽結(jié)構(gòu)殺菌抗污染
? DHA(直接氣套式)確保精確的溫度和濕度控制
外加直接加熱氣套式調(diào)節(jié)系統(tǒng),通過微電腦PID控制三個獨(dú)立加熱單元,確保了高精度高穩(wěn)定的溫度環(huán)境。

? 雙開門方式
根據(jù)使用空間和周圍儀器的放置情況,箱門可安裝成左開式或右開式。門的四角均設(shè)有隱藏式門把手,便于開啟。
日本松下(原三洋)二氧化碳培養(yǎng)箱MCO-18AC,容積:170L
內(nèi)置殺菌紫外燈(選配件)
獨(dú)特的風(fēng)道系統(tǒng)和殺菌紫外燈能夠在內(nèi)膽中保持無污染的空氣條件并改善溫度恢復(fù)特性。加濕盤中循環(huán)的空氣和水通過紫外線殺菌,以防止細(xì)菌和霉菌的蔓延。

? 可疊加使用,省空間
? 簡易的操作面板
外門中央的控制面板操作界面簡便, 便于觀察和使用。
內(nèi)膽中全圓角設(shè)計,方便清潔。
內(nèi)膽中全圓角設(shè)計,方便清潔。
? 銅合金內(nèi)膽材料—抗菌新概念
微生物污染是實(shí)驗室工作,特別是細(xì)胞培養(yǎng)工作中的敵人。在設(shè)計新型二氧化碳培養(yǎng)箱時,我們比較了通常用來抗菌的三種方法: HEPA過濾、銅及熱空氣滅菌。
HEPA過濾可以有效地去除空氣中的細(xì)菌,但需要定期更換價格不菲的HEPA過濾網(wǎng),否則會造成培養(yǎng)箱內(nèi)HEPA過濾器的細(xì)菌堆積,反而成為箱體內(nèi)的污染源;銅可以有效地抑制細(xì)菌的生長,但耐腐蝕性差,哪怕是一小滴培養(yǎng)液的溢出也足以引起其氧化腐蝕;采用熱空氣滅菌的方法則必須定期終止培養(yǎng),將所有培養(yǎng)器皿移出培養(yǎng)箱,給原本緊張的實(shí)驗工作增添麻煩。
我們提出的解決方案是采用銅合金這種結(jié)合了銅的抗菌作用和不銹鋼耐腐蝕作用的先進(jìn)材料作為二氧化碳培養(yǎng)箱的內(nèi)膽,同時減少了耗材支出,減輕了實(shí)驗室工作人員的負(fù)擔(dān)。
經(jīng)研究發(fā)現(xiàn)銅合金內(nèi)膽材料不但具有殺菌作用,對于細(xì)胞培養(yǎng)中頗為棘手的支原體同樣具有殺滅作用。在組織細(xì)胞培養(yǎng)中,由于培養(yǎng)用器皿而導(dǎo)致支原體污染的情況時有發(fā)生。二氧化碳培養(yǎng)箱的銅合金內(nèi)膽能夠在不清空培養(yǎng)箱的情況下殺滅支原體,有效地減少支原體污染的發(fā)生。
HEPA過濾可以有效地去除空氣中的細(xì)菌,但需要定期更換價格不菲的HEPA過濾網(wǎng),否則會造成培養(yǎng)箱內(nèi)HEPA過濾器的細(xì)菌堆積,反而成為箱體內(nèi)的污染源;銅可以有效地抑制細(xì)菌的生長,但耐腐蝕性差,哪怕是一小滴培養(yǎng)液的溢出也足以引起其氧化腐蝕;采用熱空氣滅菌的方法則必須定期終止培養(yǎng),將所有培養(yǎng)器皿移出培養(yǎng)箱,給原本緊張的實(shí)驗工作增添麻煩。
我們提出的解決方案是采用銅合金這種結(jié)合了銅的抗菌作用和不銹鋼耐腐蝕作用的先進(jìn)材料作為二氧化碳培養(yǎng)箱的內(nèi)膽,同時減少了耗材支出,減輕了實(shí)驗室工作人員的負(fù)擔(dān)。
經(jīng)研究發(fā)現(xiàn)銅合金內(nèi)膽材料不但具有殺菌作用,對于細(xì)胞培養(yǎng)中頗為棘手的支原體同樣具有殺滅作用。在組織細(xì)胞培養(yǎng)中,由于培養(yǎng)用器皿而導(dǎo)致支原體污染的情況時有發(fā)生。二氧化碳培養(yǎng)箱的銅合金內(nèi)膽能夠在不清空培養(yǎng)箱的情況下殺滅支原體,有效地減少支原體污染的發(fā)生。
- 細(xì)菌抗菌測試(垂滴法)

- 支原菌抗菌測試(垂滴法)


- 耐腐蝕性測試 * 銅合金不銹鋼和不銹鋼的耐腐蝕性程度相同。

- 霉菌繁殖測試結(jié)果

日本松下(原三洋)二氧化碳培養(yǎng)箱MCO-18AC,容積:170L
技術(shù)參數(shù):
| 外部尺寸 (WxDxH) | 620 x 710 x 900 (mm) |
| 內(nèi)部尺寸 (WxDxH) | 490 x 523 x 665 (mm) |
| 有效容積 | 170升 |
| 凈重 | 92公斤 |
| 耗電量 | 380W |
| 外部材料 | 彩色涂層鋼板 |
| 內(nèi)部材料 | 銅合金不銹鋼 |
| 外門 | 彩色涂層鋼板 |
| 內(nèi)門 | 強(qiáng)化玻璃 |
| 隔板 | 銅合金不銹鋼,標(biāo)準(zhǔn)3張 (較多15張) 尺寸: 長450x寬450x高12 (mm) 承重量: 7公斤/張 多段可調(diào)節(jié)式 |
| 隔熱層 | 硬質(zhì)聚亞胺酯原位整體發(fā)泡 |
| 加熱方式 | DHA方式 (直接加熱氣套式) |
| 箱內(nèi)循環(huán)方式 | 微風(fēng)攪拌方式 |
| 溫度調(diào)節(jié)方式 | PID控制方式 |
| 溫度控制范圍 | +5℃~50℃ (環(huán)境溫度:5℃~35℃) |
| 溫度均勻性 | ±0.2℃(環(huán)境溫度25℃,設(shè)定37℃, 二氧化碳5%,無負(fù)載) |
| 溫度波動幅度 | ±0.1℃(環(huán)境溫度25℃,設(shè)定37℃,二氧化碳5%,無負(fù)載) |
| 二氧化碳控制方式 | 開關(guān)控制方式 (TC傳感器) |
| 二氧化碳濃度控制范圍 | 0~20% |
| 二氧化碳濃度波動幅度 | ±0.15% (環(huán)境溫度25℃,設(shè)定37℃,二氧化碳5%,無負(fù)載) |
| 二氧化碳接口 | 內(nèi)徑4~6(mm) |
| 加濕方式 | 加濕托盤自然蒸發(fā)方式 |
| 箱內(nèi)濕度 | 95±5%R.H. (環(huán)境溫度20℃, RH60%) |
| UV殺菌紫外燈 | 4W無臭氧型 (選配) |
| 水位感應(yīng)器 | 光學(xué)反射檢測法 |
| 檢測孔 | 1個, 直徑30mm (背部) |
| 過濾器 | 0.3μm,有效率: 99.97% (二氧化碳用) |
| 報警功能 | 高/低溫報警,二氧化碳濃度波動, 門報警,獨(dú)立過熱保護(hù);紫外燈故障 |





